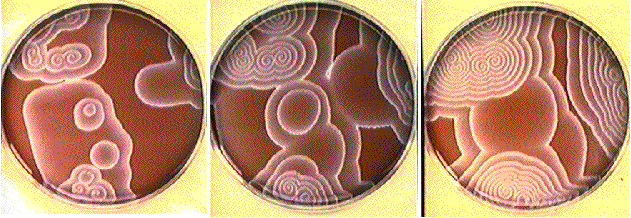
Ondes_chimiques_BZ

Cette présentation ne se veut pas exhaustive mais générale. Le lecteur intéressé par le sujet pourra utiliser les références s'il désire compléter ses connaissances. En outre, les protocoles expérimentaux des deux principales réactions sont fournis en annexe.
Des observations expérimentales mystèrieuses...
Éclaircicements thermodynamiques
Certains mélanges sont à l'origine de distributions spatiales stationnaires d'espèces chimiques même dans des systèmes monophasiques. Ces formes sont dues a des inhomogénéités de concentration des différentes espèces en solution induites par des phénomènes de diffusion relativement lents.
La différence entre les motifs obtenus est causée par l'isotropie de la diffusion. En effet, comme la diffusion peut se faire dans toutes les directions de la même manière, on obtient des formes générées aléatoirement.
Seuls les systèmes chimiques dont les
réactions possèdent des mécanismes cinétiques
présentant des boucles de rétroaction peuvent donner
naissance à des phénomènes d'auto-organisation temporelle
ou spatiale à condition qu'il soit assez loin de l'état
d'équilibre.
Le cas le plus simple de rétroaction est
l'auto- catalyse, c'est-à-dire l'activation d'une réaction
par l'un des produits qu'elle forme.
On parle de réaction chimique oscillante lorsqu'il existe des mécanismes cinétiques où entrent en compétition des processus activateurs, comme l'auto-catalyse par exemple, et inhibiteurs
L'étude des systèmes chimiques oscillants n'est pas nouvelle cependant ce n'est que récemment que l'on a pu développer les outils nous permettant de mieux les appréhender:
En 1828,Fechner observe le changement périodique de l'aspect du
fer plongé dans l'acide nitrique concentré: le métal
est terne, puis brillant, puis terne de nouveau et ainsi de suite... (Note
sur la manière d'agir de l'acide nitrique sur le fer-1833).
Schönbeim en 1836 décrit ce phénomène ainsi:
Ein so sonderbares Phänomen, wie das in Rede stehende, verdient gewifs alle Beachtung der Chemiker.
(Un phénomène aussi étrange que celui-ci mérite assurément toute l'attention du chimiste)
En 1834, Munck Af Rosenschöld constate que le phosphore émet des éclairs lumineux par intermittence avec une certaine régularité. En 1874, Joubert montre que ce phénomène est dû à l'oxydation du phosphore par l'oxygène de l'air mais ne poursuit pas l'étude plus loin.
En 1896, Raphaël Liesegang en déposant une goutte de nitrate d'argent sur du bichromate de potassium dans la gélatine découvre que la précipitation se produit sous formes d'anneaux concentriques appelés depuis anneaux de Liesegang.
En 1906, Luther en tentant de modéliser la propagation de l'influx nerveux au moyen d'une réaction dans un tube voit se développer des ondes chimiques
En 1937, Arthur Arndt en étudiant l'agrégation des amibes s'aperçoit qu'elle se produit de manière désordonnée. En fait, il observe une agitation périodique sous forme d'un motif d'onde s'enroulant autour du centre d'agrégation.
De nombreux scientifiques ont tenté par le passé de modéliser mathématiquement les réactions oscillantes. Mais les descriptions correctes ne sont apparues qu'assez récemment. Voici quelques exemples:
Il s'agit d'un modèle purement formel sans lien direct avec un sytème réel. C'est en 1910 que Lotka présenta ce modèle mais il l'améliora en 1920. Ce modèle fut ensuite repris par Volterra en 1931 pour décrire les systèmes proie-prédateur.
Il se décompose en trois étapes irréversibles:
A + X -> 2 X (k1)
X + Y -> 2 Y (k2)
Y -> P (k3)
Dans l'analogie du système proie-prédateur, il est possible d'expliciter les variables:
X: population de lapins
La reproduction est ici l'analogue d'une
réaction auto-catalytique.
A: quantité d'herbe supposée constante (ou en grand excès par rapport a sa consommation par les lapins)
Y: population en lynx
P: nombre de lynx morts
k1: constante de vitesse de reproduction des lapins
k2: constante de vitesse de reproduction des lynx
k3: taux de mortalité des lapins
Dans ce modèle, si le taux de consommation des lapins est le même que celui de reproduction des lapins, on a atteint un état stationnaire qui est comparable à ceux atteints par les réactions chimiques oscillantes auto-catalytiques.
Malheureusement ce modèle est trop simpliste et il ne peut pas être utilisé pour expliquer les réactions chimiques oscillantes. En effet, avec ce modèle on obtient toujours des oscillations, quels que soient les paramètres initiaux du système, alors qu'expérimentalement de faibles variations de ces paramètres aboutit à un système entierement différent. Ainsi il n'est pas aisé de pouvoir observer des oscillations durablement.
C'est pourquoi il a fallu découvrir d'autres modèles plus en adéquation avec l'expérience.
En 1952, Alan Turing, célèbre mathématicien anglais, dans son ouvrage The chemical basis of morphogenesis déclarait:
It is suggested that a system of chemical substances, called morphogens, reacting together and diffusing through a tissue, is adequate to account for the main phenomena of morphogenesis
( On suggère qu'un système de substances chimiques, appelés morphogènes, réagissant entre elles et diffusant à travers un tissu peuvent expliquer le principal phénomène de la morphogenèse).
Les morphogènes, substances chimiques participant à des réactions auto-catalytiques génératrices de formes, doivent diffuser plus lentement que les autres substances chimiques. Il existe un couplage entre la formation rapide de ces espèces et leur lente diffusion. Ce couplage aboutit spontanément à la formation de pics périodiques de concentration. La séparation périodique entre deux pics,appelée longueur d'onde, dépend uniquement du phénomène de diffusion. Le mécanisme proposé par Turing permet d'observer plusieurs phénomènes: structures stationnaires, oscillations, ondes chimiques.
En 1989, Vincent Castets à Bordeaux en étudiant la réaction CIMA (Chlorite-Iodure alcalin-acide MAlonique) observait dans le réacteur-gel des fronts stationnaires analogue à ceux observés dans l'écoulement de Couette (vide infra). Il était nécessaire qu'une brisure de symétrie se produise pour pouvoir apercevoir les structures prévues par Turing. A cause de la présence persistante d'une bulle dans le réacteur gel, De Kepper décida de l'agiter vivement et à sa très grande susprise, il vit apparaitre pour la première fois les structures dites de Turing qui possédaient une projection cristalline hexagonale.

En 1967, à Bruxelles, R. Lefever en compagnie de I. Prigogine et G. Nicolis, après avoir étudié le modèle de Lotka et constaté l'insuffisance du modèle de Turing qui aboutissait parfois à des concentrations d'espèces chimiques négatives, chercha un mécanisme plus simple pour obtenir des oscillations. L'étape la plus déterminante de ses recherches fut quand il songea à ajouter une étape trimoléculaire dans son mécanisme. C'est ainsi que fut créé le Bruxellateur:
A -> X (k1)
B + X -> Y + D (k2)
2 X + Y -> 3 X (k3)
réaction auto-catalytique
X -> E (k4)
Ce modèle permet de démontrer que certaines réactions chimiques peuvent être à l'origine d'une auto-organisation du système. De plus, il est désormais possible d'apercevoir des ondes chimiques et grâce à ce modèle apparait enfin un cycle limite pour le système.
Ce mécanisme est dû à R.J. Field, E. Körös et R.M. Noyes. Ils avaient décidé déétudier le mécanisme cinétique de la réaction Belousov-Zhabotinsky (vide infra) au moyen d'une électrode spécifique à l'ion bromure Br-. Après une intense compétition avec d'autres équipes dans le monde entier, ils publièrent en 1972 dans le JACS (Journal of American Chemical Society) un long article décrivant intégralement le mécanisme de la réaction en solution homogène. Ce mécanisme fut tout de suite reconnu par la communauté chimique et fut baptisé FKN selon les initiales de ses trois concepteurs.
A + Y -> X
X + Y -> P
B + X -> 2 X + Z
2 X -> Q
Z -> f Y
Pourquoi les oscillations ne peuvent être observées que loin de l'équilibre?
Quelle que soit la réaction étudiée, les lois de la thermodynamique prévalent et aucune variation spatiale ou temporelle des concentrations n'est possible en solution une fois que l'état d'équilibre est atteint. De plus, l'observation de structures chimiques spatio-temporelles est une conséquence directe de la non linéarité de l'équation de diffusion. Or près de l'équilibre on peut considérer que la diffusion suit une loi linéaire avec une bonne approximation, les phénomènes non linéaires étant négligeables: on ne peut donc observer la formation de motifs chimiques près de l'équilibre.
C'est pourquoi, pour observer des oscillations ou des motifs, il faut se placer loin de l'équilibre. Pour cela, il nous suffit d'apporter de manière constante des réactifs et d'évacuer les produits.
Dans ce but, le système utilisé par De Kepper
et al à Bordeaux est un réacteur (cf.
figure ci-dessous) constitué de deux compartiments contenant les
réactifs, séparés par un bloc de gel, qui permet d'éviter les phénomènes de mélanges convectifs dus à
l'introduction des réactifs en continu et donc de se limiter
à la diffusion seule.
On peut alors observer des formes sur la plaque de gel comme par
exemple des structures de Turing.

Les espèces chimiques impliquées dans ces réactions ont des coefficients de diffusion très différents, c'est ce qui rend l'observation de motifs chimiques possible au moyen d'indicateurs colorés.
Enfin, les oscillations observés dans ce type de réaction ne sont pas nécessairement synchrones dans toute la solution.
Pourquoi peut-on observer des motifs chimiques ?
En effet, l'observation de motifs chimiques peut sembler
contre-intuitive: A-t-on déjà vu un morceau de sucre
dissous dans une tasse se reformer ou bien s'aggreger sous forme de motifs
particuliers? La réponse évidente qui vient à
l'esprit est bien sûr non, ce n'est pas possible.
Mais alors d'où proviennent les motifs chimiques?
Le second principe de la thermodynamique impose que l'entropie totale d'un système isolé soit croissante lorsque le temps s'écoule. Par conséquent, on aurait pu penser que créer des formes particulières en solution allait à l'encontre du second principe car la création de formes augmente l'ordre du système et donc diminue son entropie.
En réalité, il n'existe pas de problème, car toute diminution de l'entropie due aux oscillations périodiques ou à la création de formes est largement compensée par l'entropie crée par les autres réactions. De plus, l'auto-organisation du système, qui se traduit par la création de formes, provoque une diminution importante de l'entropie qui peut être compensée par la dissipation d'entropie vers le milieu extérieur si bien que l'entropie finale du système soit plus grande que l'entropie initiale.
En fait, du second principe, il découle que l'enthalpie libre G doit décroître lors de l'évolution spontanée d'un système chimique. On peut donc schématiser ainsi l'évolution des concentrations au cours du temps ainsi que l évolution de l'énergie libre dans une réaction oscillante:

En 1917, à Berkeley, William C. Bray et son étudiant A. L. Caulkins observèrent que lors de la rencontre en solution aqueuse du couple diiode-iodate I2/IO3- et de l'eau oxygénée H2O2, le dégagement d'oxygène n'était pas régulier. Cependant le milieu scientifique fut très dubitatif car on pensait à l'époque que seul un milieu hétérogène pouvait être à l'origine de telles oscillations. Cette hésitation persista même après que Bray eut démontré que l'iodate était l'agent auto-catalytique.
En 1973, deux professeurs de collège Briggs et Rauscher, en cherchant un expérience de chimie amusante, eurent l'idée d'ajouter à la solution de l'amidon qui révèle la présence d'ion iodure I-.
Le mécanisme de cette réaction a été démontré par Noyes théoriquement. Depuis, elle a été à la base de nombreuses autres réactions encore étudiées aujourd'hui dont la réaction CIMA utilisée par l'équipe de De Kepper pour découvrir les structures de Turing.
Son mécanisme simplifié est le suivant:
IO3- + 2 H2O2 + H+ = HOI + 2 O2 + 3 H2O :(A)
HOI + CH2(CO2H)2 = ICH(CO2H)2 + H2O :(B)
On peut expliquer la présence des oscillations grâce au diagramme suivant:

Il s'agit d'une réaction chimique dont le mécanisme n'est pas linéaire et qui peut être décomposée en une quarantaine d'actes élémentaires environ. Elle fut découverte par un biologiste russe du nom de Belousov qui étudiait le cycle de Krebs dans un laboratoire dépendant directement de l'Armée Rouge. Le cycle de Krebs est un mécanisme biochimique complexe intervenant dans le métabolisme des sucres dont le glucose. Belousov cherchait à comprendre le rôle de l'acide citrique qui est oxydé dans ce cycle. Il pensa le doser grâce au bromate de potassium KBrO3 mais la réaction était trop lente et il ajouta du Ce4+ pour la catalyser. Mais il constata alors que le milieu réactionnel changeait de couleur périodiquement. Il entreprit alors un étude approfondie en variant le pH de la solution et en ajoutant de la ferroine (indicateur coloré d'oxydo-réduction à base de Fe2+). Cependant toute ses tentatives de publications furent refusées par des jurys hostiles à l'idée d'oscillations chimiques. Cependant avant d'abandonner ses recherches il publia une note dans un journal méconnu Sbornik Referatov po Radiaconi Medecine
En 1961, un jeune biophysicien, A. Zhabotinsky, s'intéressait au phénomènes oscillants dans les milieux biologiques. Il contacta donc, sur les conseils de son supérieur S. Schnoll, Belousov qui lui indiqua les références de sa publication. En quelques mois, Zhabotinsky réussit à obtenir des oscillations et à montrer que l'acide citrique pouvait être substitué par l'acide malonique. Il publia ses résultats dans Biophysika en 1962. Il poursuivit ensuite son étude plus avant grâce à l'aide de ses collaborateurs dont Zaïkin, Vavilin et Krinsky
Voici la description de cette réaction:
Première phase:
Br- + BrO3- + 2 H+ -> HBrO2 + HOBr
Br- + HBrO2 + H+ -> 2 HOBr
Br- + HOBr + H+ -> Br2 + H2O
Br2 + HOOCCH2COOH -> HOOCCHBrCOOH + Br- + H+
L'acide bromique HBrO2 réagit avec une grande quantité de Br-(la concentration en Br- diminue). Ceci entraine la bromation de l'acide malonique (dernière étape)
Deuxième phase:
BrO3- + HBrO2 + H+ -> 2 Br O2 + H2O
BrO2 + Fe2+ + H+ -> Fe3+ + HBrO2
2 HBrO2 -> HOBr + BrO3- + H+
Du fait de la baisse de concentration en ion bromure Br-, l'acide bromique ne peut plus réagir comme auparavant. Il forme donc, en se combinant avec le bromate BrO3-, le radical BrO2 qui permet l'oxydation des ions Fe2+ en Fe3+
Troisième phase:
2 Fe3+ + HOOCCHBrCOOH + HOOCCH2COOH + 3 H2O -> 2 Br- + 2 Fe2+ + 3 HOOCCHOHCOOH + 4 H+
Quand la concentration en Fe3+ commence à devenir importante, Fe3+ est alors réduit en Fe2+ avec production d'ions bromures Br- . L'augmentation de leur concentration stoppe alors la progression de la deuxième phase en favorisant la première. Ainsi les ions bromure Br- permettent alors d'initier un nouveau cycle.
Voici la courbe d'évolution des espèces:

Plus tard,Noyes, en visite au Max Planck Institut de Dortmund à l'occasion d'un congrès, eut la possibilité de voir une étude de la réaction de Belousov-Zhabotinsky au moyen d'un système Ultra-Violet dans le laboratoire de Müller. Il lui demanda de s'intéresser au coeur des spirales. Un peu plus tard, Noyes montra qu'il y existait une singularité.
En 1970, A.T. Winfree, biologiste à Princeton, en étudiant un fungus s'aperçut que ce dernier croissait en cercles concentriques et formait parfois des spirales. C'est alors qu'il découvre un article publié par Zaikin et Zhabotinsky. Winfree essaya ensuite de montrer que le phénomène observé chez le fungus n'était pas de nature chimique. Mais il doit se rendre à l'évidence et publie en 1972 dans Science les spirales obtenues dans la boite de Petri (comme celles que l'on peut apercevoir dans la toute première illustration). Ce fut un choc dans le monde scientifique occidental mais ces observations n'étaient pas nouvelles pour les russes qui n'avait pas communiqué leurs résultats du fait de la Guerre Froide.

Il semble aussi que des réactions analogues à celles développées ci-dessus soient à l'origine des taches ou des rayures que présentent les animaux sur leur pelage. On a, par exemple, pu démontrer que les taches du guépard étaient dues à de tels phénomènes. Cependant la généralisation de ces résultats ne peut être effectuée qu'avec prudence.